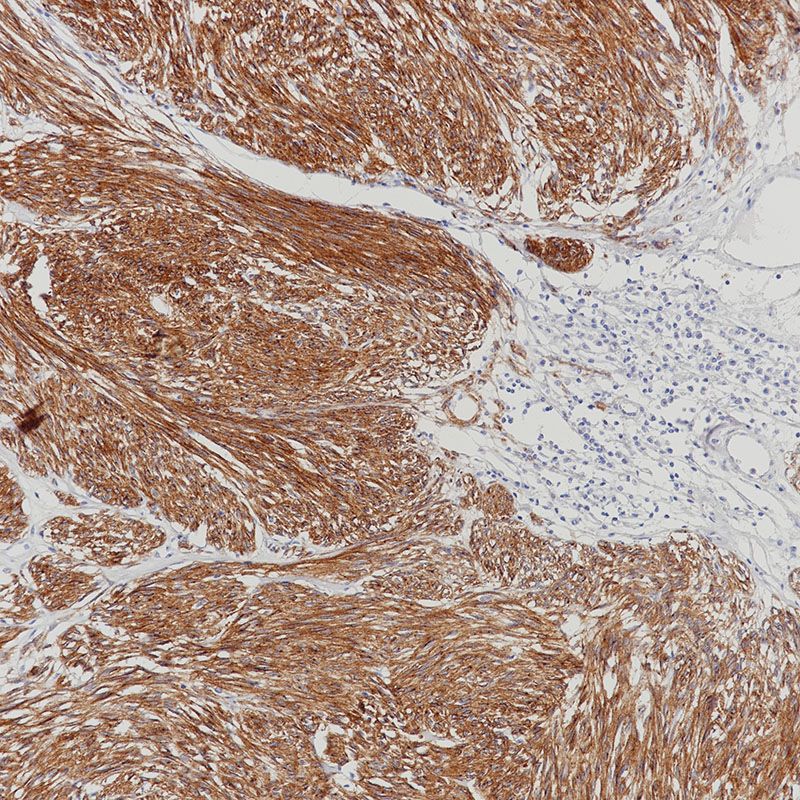
CD117

相关产品推荐更多 >
万千商家帮你免费找货
0 人在求购买到急需产品
- 详细信息
- 技术资料
- 免疫原:
peptide
- 亚型:
IgG
- 形态:
Liquid
- 保存条件:
-20℃
- 克隆性:
mAb
- 适应物种:
Human
- 保质期:
1年
- 目录编号:
TD-R50063
- 级别:
科研级
- 库存:
88
- 供应商:
武汉天德
- 宿主:
Rabbit
- 应用范围:
IHC-P
- 靶点:
详询
- 抗体英文名:
CD117
- 抗体名:
CD117
- 规格:
100ul/50ul
| 规格: | 100ul | 产品价格: | ¥2880.0 |
|---|---|---|---|
| 规格: | 50ul | 产品价格: | ¥1880.0 |
CD117 Rabbit mAb
|
Product Name
|
CD117 Rabbit mAb
|
|
Gene ID
|
3815
|
|
SwissProt ID
|
P10721
|
|
Gene Name
|
KIT
|
|
Alternative Names
|
KIT; SCFR; Mast/stem cell growth factor receptor Kit; SCFR; Piebald trait protein; PBT; Proto-oncogene c-Kit; Tyrosine-protein kinase Kit; p145 c-kit; v-kit Hardy-Zuckerman 4 feline sarcoma viral oncogene homolog; CD antigen CD117
|
|
Background
|
KIT encodes the human homolog of the proto-oncogene c-kit. C-kit was first identified as the cellular homolog of the feline sarcoma viral oncogene v-kit. KIT is a type 3 transmembrane receptor for MGF (mast cell growth factor, also known as stem cell factor). Mutations in KIT are associated with gastrointestinal stromal tumors, mast cell disease, acute myelogenous lukemia, and piebaldism.
|
|
Research Field
|
Immunology
|
|
Product Categories
|
Pathological antibody
|
|
Host
|
Rabbit
|
|
Reactivity
|
Human
|
|
Application
|
IHC-P
|
|
Dilution Ratio
|
IHC: 1/100-1/200
|
|
Molecular Weight
|
-
|
|
Clonality
|
Monoclonal Antibody
|
|
Clonality No.
|
BP6064
|
|
Isotype
|
IgG
|
|
Immunogen
|
A synthesized peptide derived from human KIT
|
|
Purification
|
Affinity Purified
|
|
Conjugation
|
Unconjugated
|
|
Modification
|
Unmodified
|
|
Form
|
Liquid
|
|
Buffer System
|
Liquid in PBS containing 50% glycerol, 0.5% BSA and 0.02% sodium azide, pH 7.3.
|
|
Storage
|
Store at 4°C short term. Aliquot and store at -20°C long term. Avoid freeze/thaw cycles.
|
风险提示:丁香通仅作为第三方平台,为商家信息发布提供平台空间。用户咨询产品时请注意保护个人信息及财产安全,合理判断,谨慎选购商品,商家和用户对交易行为负责。对于医疗器械类产品,请先查证核实企业经营资质和医疗器械产品注册证情况。
技术资料暂无技术资料 索取技术资料
CD117
¥1880 - 2880